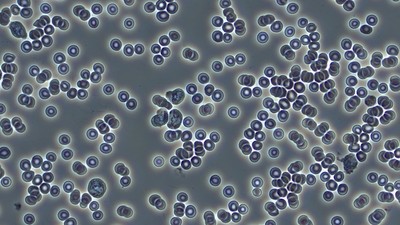

Ever Wonder What's Really Happening Inside Your Body?
Hi, I’m Cindy. I use Live Blood Microscopy to uncover what’s going on beneath the surface.
Living with chronic pain, stress, or stubborn weight can be confusing and frustrating. Sometimes it feels like you’re doing everything right — but your body isn’t responding. Live Blood Microscopy gives real-time insights into your nutrition, inflammation, immunity, and stress levels. Together, we’ll use this information to create a clear, personalized path toward better health.
What Is Live Blood Microscopy?
Live Blood

Dry Blood (Oxidative Stress Test)

Blood Type & DNA Insight
What You'll Discover
Your blood tells a story — and within it are clues that help guide your health choices:
Nutritional Imbalances
Immunity
Digestion
Inflammation
Microbiome
Stress
Hydration
Why It Matters?
See Clarity. Find Balance. Live Well.
When you can actually see what's happening in your body, everything clicks.
These insights make it easier to choose the right nutrition and strategies to restore balance, reduce inflammation, and boost energy.
How It Fits With Metabolic Balance®
When You See It. You Can Change It.
Live Blood Microscopy often reveals nutritional imbalances that can be directly addressed through the Metabolic Balance® program. Together, these services provide clear insights and practical steps to improve digestion, reduce inflammation, and support weight balance.
I guide you through your results with compassion, making them simple to understand and easy to apply — so you feel confident and empowered every step of the way.
Your Next Step
Book your Live Blood Microscopy session today!
Take the first step toward reducing inflammation, easing pain, boosting energy, and reclaiming your vitality.